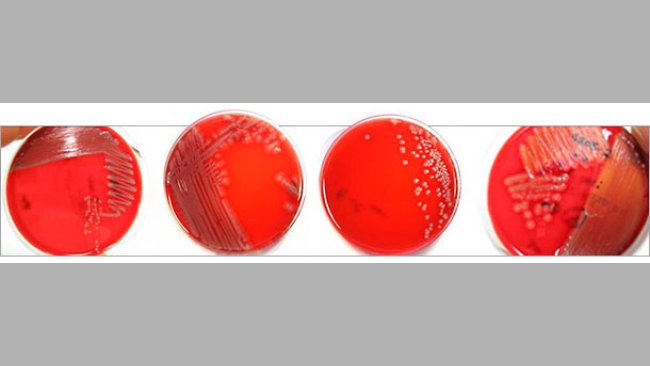
Morfologia różnych kolonii patogennych izolatów E.coli

Występowanie patogenów bakteryjnych i wirusowych w biegunkach prosiąt ssących - wyniki europejskiego programu monitorowania
Wyniki programu monitorowania oceniającego występowanie E. Coli, C. perfringens, rota i koronawirusów powodujących biegunki noworodkowe u prosiąt.